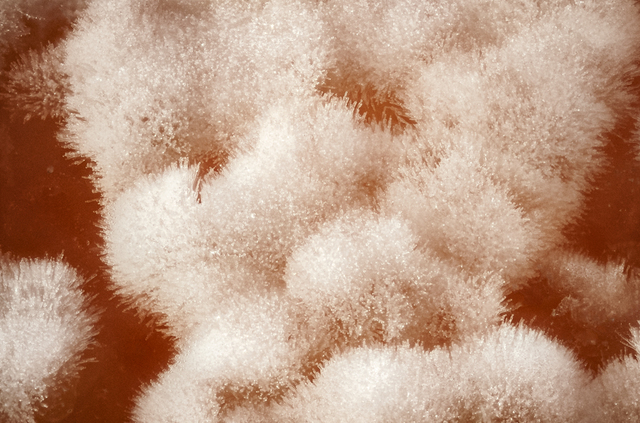
Primer descobriment de Darwin

-
Charles Darwin fill de Susannah Darwin i Robert Darwin, va néixer a La Muntanya, Shrewsbury, Regne Unit
-
La mare de Darwin després d'un llarg període lluitant contra el càncer, va morir a causa d'un càncer d'estómac.
-
Darwin s'incorpora amb el seu germà Erasmus a la propera escola anglicana de Shrewsbury com a pupil i en aquesta escola és on passarà els 7 pròxims anys.
-
17 JUNY: Robert Darwin, el seu pare, va treure a Darwin de l'escola juntament amb el seu germà Erasmus.
22 OCTUBRE: Es matricula amb el seu germà Erasmus a la Universitat d'Edimburg -
Durant la seva estància a Edimburg, Darwin va ingressar a la Universitat d'Edimburg per estudiar medicina per decisió del seu pare, però Darwin no va aconseguir interessar-se per la cursa.
-
Va presentar davant la Societat Pliniana el descobriment que unes espores blanques trobades en closques d'ostres eren els ous d'una sangonera.
-
Darwin a punt de complir els 20 anys va entrar al Christ's College de Cambridge.
És una de les trenta "collages" que formen part de la universitat de Cambridge. -
Després de passar l'examen de BA, va seguir a Cambridge durant dos mandats.
Darwin torna a Shrewsbury de Gales a trobar una carta de Henslow que el convida a unir-se al viatge del Beagle
Aquesta dada va ser molt important en la vida de Darwin i li va marcar molt el seu futur, va pujar a bord del Beagle amb rumb a l'Amèrica del Sud. -
Durant aquest viatge, Darwin va visitar diversos llocs:
- Santiago de Cap Verd - Illes de Cap Verd
- Roques de Sant Pere i Sant Pau
- Rio de Janeiro
- Maldonado, Uruguai
- Des Riu Negre (Uruguai) a Bahía Blanca
- Badia Blanca
- De Badia Blanca a Buenos Aires
- Buenos Aires i Santa Fe
- Banda Oriental i Patagònia
- Santa Creu, Patagònia argentina, i les Illes Malvines
- Terra del Foc
- Estret de Magallanes, el clima dels mars del sud (No estan ordenats per data ni apareixen tots)
-
Darwin va tenir ocasió de demostrar els seus coneixements geològics al mes següent, quan el Beagle va aconseguir la costa argentina de Punta Alta. Allà, en un petit terraplè d'uns sis metres d'altura, va desenterrar fòssils de mamífers extints.
-
Es casa amb la seva promesa esposa Emma Wedgwood.
-
Publica el seu llibre que era el seu diari d'investigacions que va anar anotant a el llarg del transcurs del viatge, per aquesta raó va rebre el nom de:
<El Viatge del Beagle> Darwin remarca que aquest viatge li va canviar la vida. -
El pare de Darwin va morir per insuficiència cardíaca.
-
Comença a redactar els seus punts de vista per elaborar un gran projecte d'un llibre anomenat: Selecció natural.
-
Alfred Russel Wallace va enviar una carta a Darwin exposant la seva pròpia teoria de l'evolució i Darwin va veure que hi havia moltes coses en comú.
-
L'origen de les espècies per mitjà de la selecció natural o la preservació de les races afavorides en la lluita per la vida es publica a Londres per John Murray.
Va exposar la seva teoria de la biologia evolutiva en el llibre anomenat: L'origen de les espècies.
Segons aquest procés, els individus més ben adaptats al medi tenien més probabilitats de sobreviure que els que no. -
-
-
-
-
Publica el llibre anomenat L'origen de l'home on aplica la teoria de l'evolució i la selecció natural a l'evolució humana.
-
-
Va publicar el seu llibre sobre les plantes carnívores/insectívores, i un llarg assaig sobre els efectes de l’autofertilització en el regne vegetal.
-
Charles Darwin juntament amb el seu fill Francis Darwin van publicar el llibre The Power of Movements in Plants en Anglès i La capacitat de moviment en les plantes en Català.
-
-
Charles Darwin va morir per insuficiència cardíaca, reconegut com un dels científics més importants de la història de la humanitat. Va morir a Down House, Downe, Regne Unit